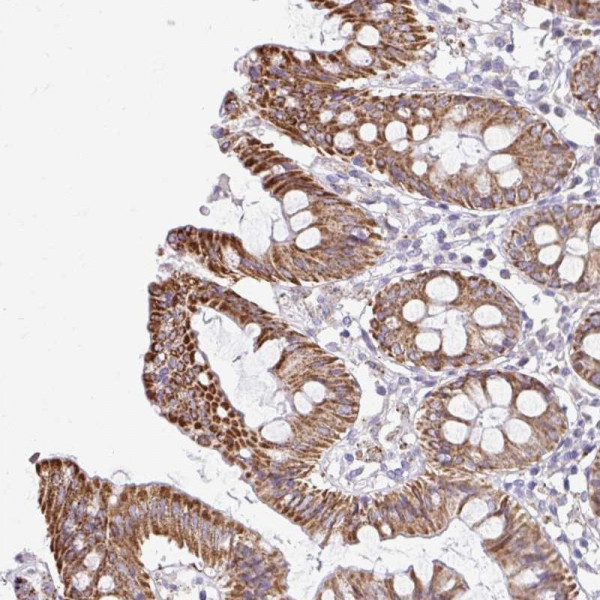
Anti-NT5C1B

| Item number | Size | Datasheet | Manual | SDS | Delivery time | Quantity | Price |
|---|---|---|---|---|---|---|---|
| ATA-HPA056683.25 | 25 µl | - |
7 - 10 business days* |
246.00€
|
|||
| ATA-HPA056683.100 | 100 µl | - |
7 - 10 business days* |
491.00€
|
If you have any questions, please use our Contact Form.
You can also order by e-mail: info@biomol.com
Larger quantity required? Request bulk
You can also order by e-mail: info@biomol.com
Larger quantity required? Request bulk
Viewed